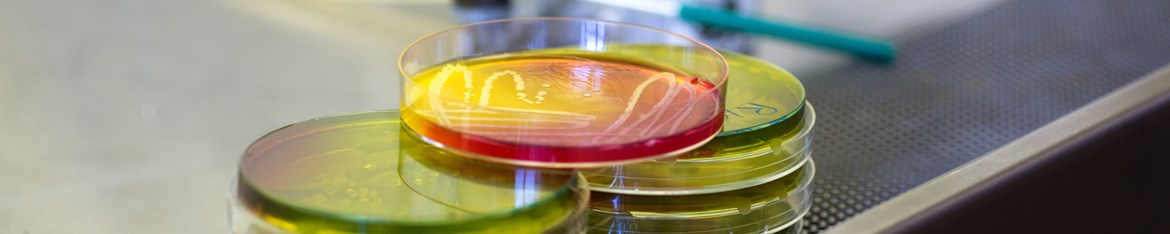

Los objetivos del grupo se orientan a la mejora de la seguridad microbiológica de alimentos. Se abordan estrategias de procesado mínimo, tecnologías de altas presiones, sistemas inhibitorios biológicos y tratamientos combinados.
Se desarrollan técnicas moleculares para la detección de microorganismos patógenos y su trazabilidad a lo largo de la cadena alimentaria, se investigan medidas de control de contaminaciones persistentes en la industria y se estudia la virulencia de Listeria monocytogenes.
- Landete JM, Monedero V, Ferrer S, Zúñiga M. Malic enzyme and malolactic enzyme pathways are functionally linked but independently regulated in Lactobacillus casei BL23. Applied and Enviromental Microbiology (En prensa).
- Landete JM, Arqués JL, Medina M, Gaya P, de las Rivas B, Muñoz R. Bioactivation of phytoestrogens: intestinal bacteria and health. Critical Reviews in Food Science and Nutrition (En prensa).
- De Alba M, Bravo D, Medina M (2013). Inactivation of Escherichia coli O157:H7 in dry-cured ham by high pressure treatments combined with biopreservatives. Food Control 31, 508-513.
- Langa S, Landete JM, Martín-Cabrejas I, Rodríguez E, Arqués JL, Medina M (2013). In situreuterin production by Lactobacillus reuteri in dairy products. Food Control 33, 200-206.
- Fernández F, Langa S, Martín V, Maldonado A, Jiménez E, Martín R, Rodríguez JM. (2013). The human milk microbiota: Origin and potential roles in health and disease. Pharmacological Research 69, 1-10.
- Montiel R, Bravo D, Medina M. (2013). Commercial biopreservatives combined with salt and sugar to control Listeria monocytogenes during smoked salmon processing. Journal of Food Protection 75, 1463-1465.
- Montiel R., Cabeza M.C., Bravo D., Gaya P., Cambero I., Ordóñez J.A., Nuñez M., Medina M. (2013). A comparison between E-beam irradiation and high pressure treatment for cold-smoked salmon sanitation: shelf-life, colour, texture and sensory characteristics. Food and Bioprocess Technology 6, 3177-3185.
- Del Olmo, Ana. 2012. Evaluación del efecto antimicrobiano de la lactoferrina bovina y sus derivados, y su combinación con altas presiones, sobre patógenos y alterantes de la carne y productos cárnicos. Director: Manuel Nuñez. Facultad de Veterinaria, Universidad Complutense de Madrid.
- Montiel Moreno, Raquel. 2010. Listeria monocytogenes en salmón ahumado: detección en la industria y eliminación en el producto mediante altas presiones y bioconservación. Directores: Dra. Margarita Medina y Dr. Daniel Bravo. Facultad de Veterinaria. Universidad Complutense de Madrid.
- Navas Fernández, Jaime. 2007. Detección molecular de Listeria monocytogenes en carne de pollo. Diversidad genética y virulencia de cepas aisladas. Directores: Dr. Joaquín V. Martínez y Dra. Victoria López. Facultad de Veterinaria. Universidad Complutense de Madrid.
- Margarita Medina, Eva Rodríguez, Angela Peirotén, Juan Luis Arqués. Título: Microorganismo aislado de leche materna y de heces de un lactante y su uso como probiótico N. de solicitud: P201231747 País de prioridad: España Fecha de prioridad: 13/11/2012 Entidad titular: INIA
Noticias

Bacteriocinas de bacterias lácticas: bioconservantes naturales
Ante la demanda de los consumidores de alimentos seguros, mínimamente procesados, con una vida útil larga y sin aditivos químicos, el empleo de las bacteriocinas como bioconservantes en alimentos representa una alternativa para prevenir el desarrollo de microorganismos patógenos y alterantes.

Tecnologías emergentes para garantizar la seguridad microbiológica de alimentos
Las enfermedades transmitidas por alimentos representan un problema de salud pública. Los alimentos listos para el consumo (RTE, del inglés “ready to eat”) son responsables de una proporción considerable de las toxiinfecciones alimentarias que se producen.